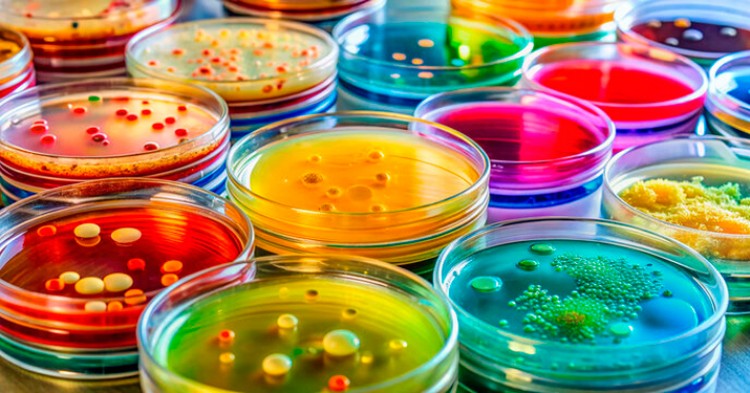

10 cosas que debes saber sobre la Biotecnología
La Biotecnología es una ciencia que usa seres vivos, como bacterias, plantas o células, para crear productos útiles o resolver problemas en la salud, la agricultura, el ambiente y…
La Biotecnología es una ciencia que usa seres vivos, como bacterias, plantas o células, para crear productos útiles o resolver problemas en la salud, la agricultura, el ambiente y…
La Eficiencia Energética es la capacidad de utilizar la menor cantidad de energía posible para realizar una actividad o satisfacer una necesidad, sin comprometer el rendimiento, la calid…
La Informática se define como la ciencia que estudia el tratamiento automático de la información mediante el uso de dispositivos electrónicos y sistemas computacionales. Su…
Ciberseguridad es el conjunto de prácticas, tecnologías y procesos diseñados para proteger sistemas, redes, dispositivos y datos de ataques cibernéticos, accesos no autoriz…
La Energía se define como la capacidad de realizar trabajo o producir cambios en un sistema. Es una magnitud física fundamental que puede manifestarse de diversas formas, como Energ&iacu…
Los Videojuegos son formas de entretenimiento digital interactivo que se juegan mediante dispositivos electrónicos, como computadoras, consolas de Videojuegos, teléfonos móviles y…
La Energía Nuclear es la energía liberada durante los procesos de fusión o fisión nuclear, que se utilizan principalmente para generar electricidad. En los reactores nuclea…
Internet es una red global de redes de computadoras interconectadas que permite la comunicación y el intercambio de información entre dispositivos a través de protocolos estandari…
Cargando